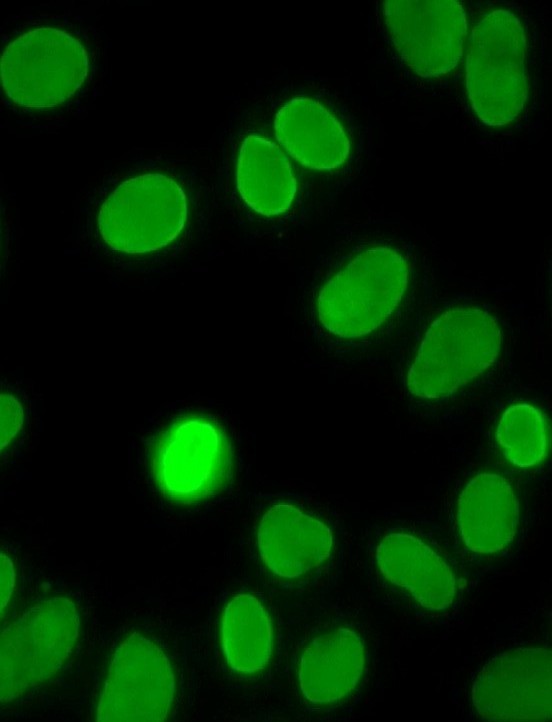
PSG tweet media

🦟 Tropical diseases don't stay in the tropics. Validate your Dengue and Chlamydia assays with PSG’s infectious disease panels. Global sourcing, local delivery.
#GlobalHealth #InfectiousDisease #Dengue #PSGexpertise #Fujirebio
English
PSG
269 posts

@PlasmaServices
PSG is the premier bridge between patients with autoimmune, infectious, and clotting disorders and the diagnostics industry.